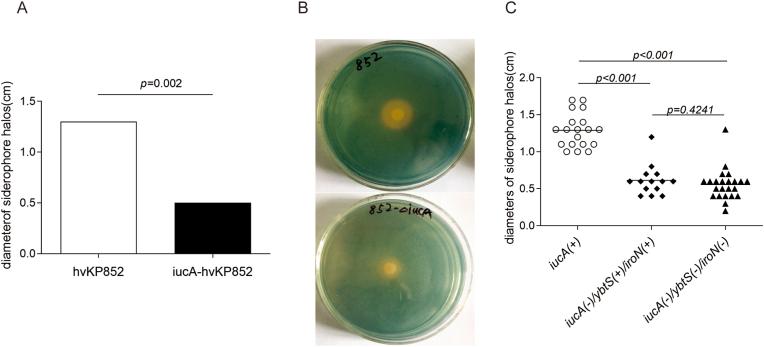
https://cdn.ncbi.nlm.nih.gov/pmc/blobs/25e2/9634269/7e1e739fb1b1/gr2.jpg

高黏液性铁载体通过诱导氧化应激促进小鼠肝脏损伤。
Siderophore of hypermucoviscous promotes liver damage in mice by inducing oxidative stress.
作者信息
Wu Jinyin, Chen Jie, Wang Ying, Meng Qingtai, Zhao Jizi
机构信息
Wu Lien Teh Institute, Department of Microbiology, Harbin Medical University, 157, Baojian Road, Nangang District, Harbin, 150081, China.
Heilongjiang Provincial Key Laboratory of Infection and Immunity, Pathogen Biology, Harbin, China.
出版信息
Biochem Biophys Rep. 2022 Oct 29;32:101376. doi: 10.1016/j.bbrep.2022.101376. eCollection 2022 Dec.
The hypermucoviscosity/hypervirulent (hvKP) is a dominant cause of pyogenic liver abscess (PLA) and has contributed to the endemicity of disease in Asian country. The siderophore aerobactin () is highly expressed in hvKP and acting virulence role during hvKP infection. However, its role in the PLA is poorly understood. We constructed deletion mutant (-hvKP852) and used animal study to characterize the role of siderophore in liver abscess. The animal experiments showed that -hvKP852 strain had lower virulence in mice compared to hvKP852 wild type strain. At 24 h after infection, only two of ten mice developed liver abscess during infection with -hvKP852 strain, while nine of ten mice infected with wild type hvKP852 strain showed multiple lesions of liver abscess. The liver tissue infected with -hvKP852 exhibited low reactive oxygen stress levels compared to those infected by wild type hvKP852 strain ( < 0.05). The results suggest that siderophore play an important role in the liver abscess by inducing oxidative stress.
高黏液性/高毒力肺炎克雷伯菌(hvKP)是化脓性肝脓肿(PLA)的主要病因,并导致了亚洲国家该病的流行。铁载体气杆菌素(aerobactin)在hvKP中高度表达,并在hvKP感染过程中发挥毒力作用。然而,其在PLA中的作用尚不清楚。我们构建了气杆菌素缺失突变体(Δ-hvKP852),并通过动物研究来表征铁载体气杆菌素在肝脓肿中的作用。动物实验表明,与hvKP852野生型菌株相比,Δ-hvKP852菌株在小鼠中的毒力较低。感染后24小时,用Δ-hvKP852菌株感染的10只小鼠中只有2只在感染期间发生肝脓肿,而用野生型hvKP852菌株感染的10只小鼠中有9只出现多处肝脓肿病变。与野生型hvKP852菌株感染的肝脏组织相比,Δ-hvKP852感染的肝脏组织表现出较低的活性氧应激水平(P<0.05)。结果表明,铁载体气杆菌素通过诱导氧化应激在肝脓肿中起重要作用。